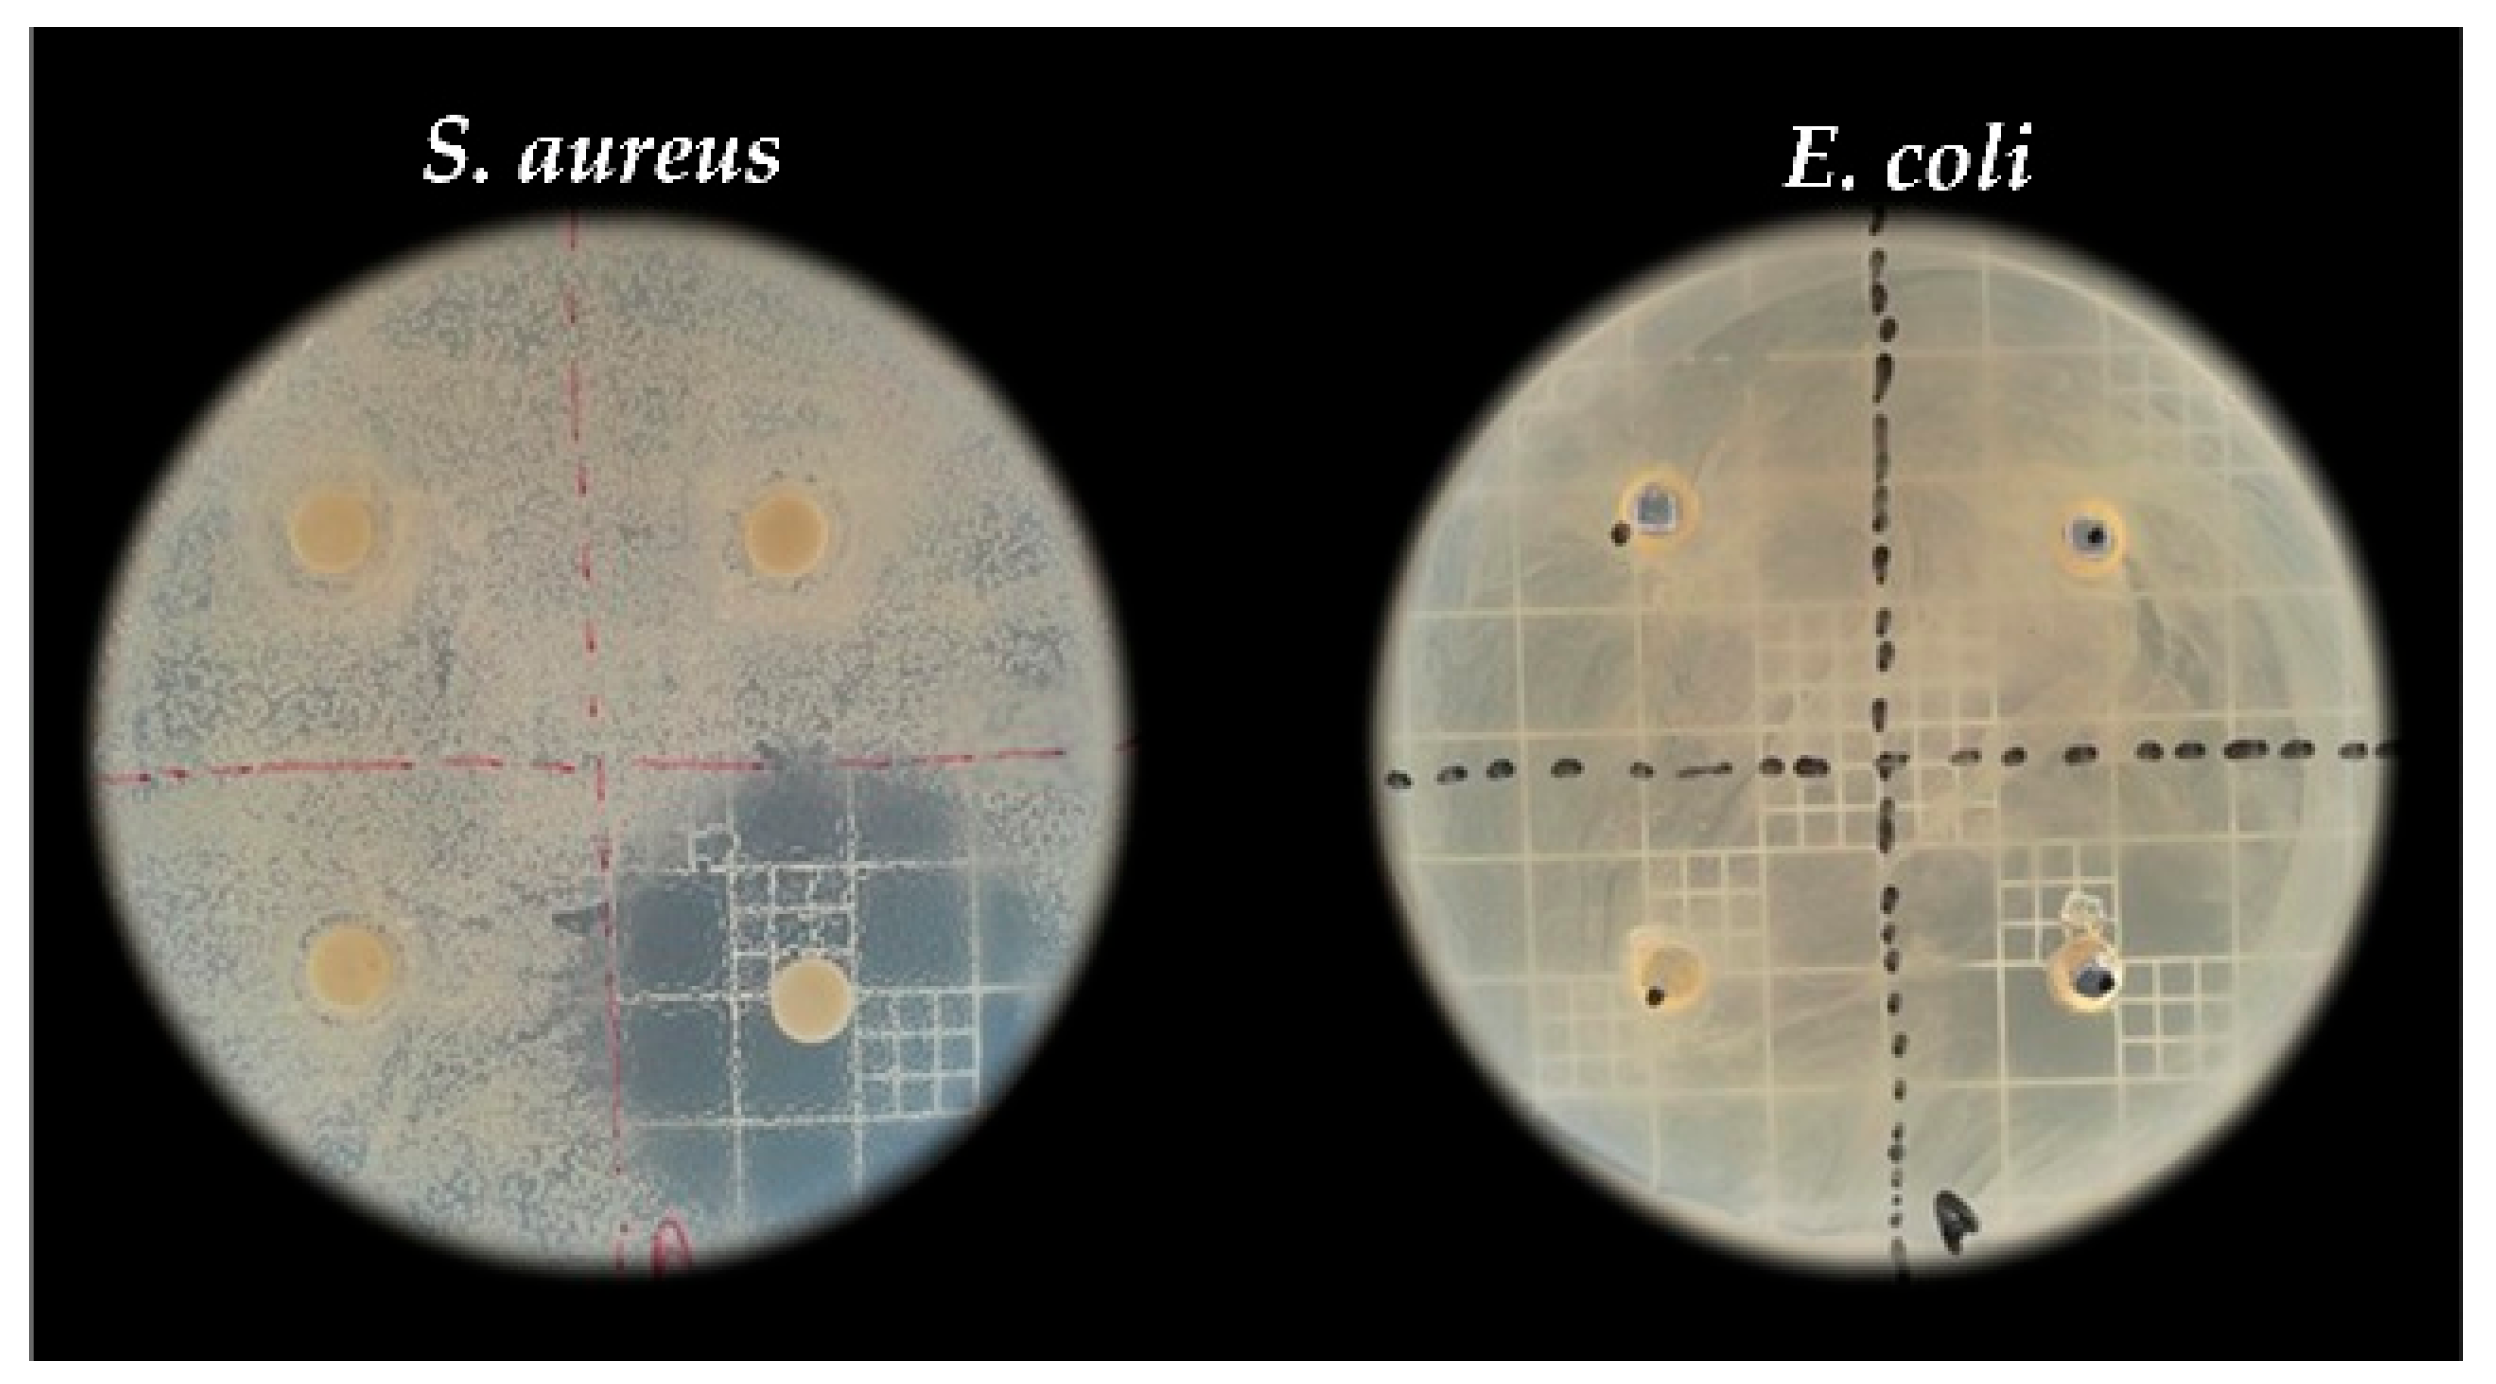
Processes 13 01815 g003

Abstract
The demand for sustainable, low-cost bioprocesses has encouraged the development of alternative enzyme production strategies. This study investigated the purification and characterization of a crude enzymatic extract (CEE) rich in α-amylase from Coprinus comatus, using wheat milling by-products as substrate. The CEE was obtained by submerged culture, followed by biomass removal, centrifugation, and ultrafiltration to yield a partially purified enzyme (PE). CEE and PE were evaluated for chemical composition, antioxidant and antibacterial activity, toxicity (Artemia salina assay), and enzymatic performance. Toxicity assays confirmed that CEE was non-toxic. Antioxidant activity reached 213.34 µmol TE·gDE−1 (DPPH assay), with a total phenolic content of 8.01 mg GAE·gDE−1. No antibacterial activity was detected. CEE hydrolyzed 96.31% of starch in 180 min, releasing 10.85 g·L−1 glucose, while PE achieved 98% hydrolysis and released 14.5 g·L−1. Optimal α-amylase activity occurred at 50 °C and pH 5.5 (CEE) or 5.0 (PE). Calcium ions improved the enzymatic activity and thermal stability. CEE retained over 60% activity after 721 days under refrigeration (4 °C) or freezing (0 °C). Although lyophilization enhanced enzyme concentration, it increased production costs. SDS-PAGE revealed bands of ~67 kDa (α-amylase) and ~35 kDa (glucoamylase). These findings support the use of CEE as a sustainable, low-cost biocatalyst for industrial use.
1. Introduction
The growing demand for sustainable and cost-effective biotechnological processes has increased interest in enzymes, particularly those with industrial applications, such as α-amylases. These enzymes are especially relevant due to their ability to hydrolyze starch, releasing glucose, maltose, and oligosaccharides [1]. α-Amylases are widely used to produce glucose syrup, sweeteners, bakery products, and starch hydrolysis [2,3,4,5]. In 2023, the global α-amylase market was valued at USD 10.54 billion, with projections to reach USD 17.55 billion by 2030 [6], highlighting its importance and prominence in the food industry.
The international market for α-amylases is promising, but Brazil shows a contrasting picture: approximately 86% of companies import technology and inputs for enzyme production [7]. In this context, the vast diversity of underexplored microorganisms, combined with the availability of alternative substrates of national origin, justifies and has been driving research focused on producing enzymes with industrial relevance. Moreover, reducing the costs associated with the production, purification, and formulation steps is essential to make α-amylases competitive in the market.
In this scenario, Coprinus comatus stands out as a promising macrofungi for its potential as an edible species and ability to produce high-value biomolecules [8,9]. Furthermore, this fungus is known for its extracellular enzyme production, although its capacity to synthesize enzymes such as amylases has remained underexplored in the literature. These characteristics make it a strategic alternative for low-cost enzymatic products that can be developed through simplified processes and minimal purification steps. Furthermore, C. comatus has been used in soil bioremediation strategies for contaminated sites, confirming its environmental applicability [10,11]. Studies on this strain also highlight its medicinal potential—including antitumor activity, protection against alcohol-induced liver damage, and blood glucose regulation—and its ability to produce valuable enzymes [12,13,14,15]. Moreover, this macrofungus’s residual biomass and metabolites—such as industrially relevant enzymes and nutraceutical compounds—can be transformed into high-value products, underscoring its considerable economic potential.
One key factor influencing enzyme production costs is the price of the substrate. An effective strategy to reduce costs involves the use of agro-industrial by-products. Wheat production in the 2021/2022 season reached 775.3 million tons [16,17]. Approximately 75% of processed wheat is directed toward flour production [17]. The remaining fraction constitutes residues and by-products, which accounted for around 180 million tons in 2018 [15,16], representing a promising low-cost substrate source. The production of α-amylase by C. comatus using wheat milling by-products has been previously reported by Frantz et al. [15] and Paludo et al. [18], but studies evaluating the enzyme in both purified and crude extract forms for industrial applications remain limited.
Purification is directly associated with process costs; the higher the degree of purification, the more expensive the process becomes [19,20]. While purification steps are important for ensuring safety in food applications, alternative strategies can be evaluated to ensure safety without requiring extensive purification. Therefore, characterizing the crude enzymatic extract (CEE) becomes essential, along with the judicious selection of purification steps, when necessary.
Therefore, this study aimed to obtain a CEE rich in α-amylase produced by C. comatus using a wheat milling by-product as a substrate and to characterize it in terms of enzymatic activity, storage stability, toxicity, proximate composition, antioxidant activity, and antimicrobial potential. Furthermore, the CEE was compared with a partially purified enzyme, obtained through minimal steps, to evaluate its applicability and potential for reducing production costs. It is worth emphasizing that this study is a preliminary step toward developing a novel product for this market, and further investigations are needed to explore its industrial applications.
2. Materials and Methods
Figure 1 presents a flowchart summarizing the steps involved in the production, characterization, and purification of the CEE, and the functional analysis of the purified enzyme (PE). The process begins with the production of the enzymatic extract, followed by the characterization of the CEE, including assessments of chemical composition, toxicity, antioxidant activity, antibacterial activity, and storage stability. In parallel, the extract undergoes a purification process to isolate the amylase enzymes.
Figure 1.
Flowchart illustrating the steps involved in the production, characterization, and purification of the CEE and the functional evaluation of the PE.
The comparative characterization of the enzyme present in the CEE and the PE encompasses evaluating the effects of temperature, pH, and metal ions on enzymatic activity, thermal stability analyses, and the feasibility of lyophilization. Additionally, the functional capacity for starch hydrolysis is assessed by quantifying glucose release. Finally, the molecular weight of the proteins in PE is determined through sodium dodecyl sulfate-polyacrylamide gel electrophoresis (SDS-PAGE). These experimental analyses comprehensively characterize the enzymatic extract and the associated amylase, supporting their potential application in biotechnological processes.
2.1. Materials and Microorganisms
The C. comatus strain was donated by the Mushroom Bioprocesses Laboratory of the Universidade Estadual do Centro Oeste (UNICENTRO). The low-grade flour (LGF)—13.24% moisture, 2.68% ashes, 18% protein, 63.91% starch [15]—an agro-industrial by-product, was supplied by a wheat milling company located in Curitiba, Paraná, Brazil. All reagents used for the antioxidant analysis were purchased from Sigma-Aldrich® (St. Louis, MO, USA).
2.2. Production of the Crude Enzymatic Extract (CEE)
The inoculum preparation, maintenance of C. comatus, and the production of the CEE were conducted following the methodology described by Frantz et al. [15], with modifications in substrate concentrations. The culture medium consisted of 48.5 g·L−1 of LGF, 4.0 g·L−1 of urea (≥99.5% purity, Dinâmica Química Contemporânea, Diadema, SP, Brazil), and 8.0 g·L−1 of dipotassium phosphate (K₂HPO₄, ≥99.0% purity, Synth, Diadema, SP, Brazil), with the pH adjusted to 6 using 2M hydrochloric acid (HCl, 37% w/w, Dinâmica Química Contemporânea, Diadema, SP, Brazil) or 2M sodium hydroxide (NaOH, ≥98.0% purity, Neon Reagentes Analíticos, Suzano, SP, Brazil). The medium was inoculated with 0.5% (w/v) of C. comatus and incubated in an orbital shaker (TE-24, TECNAL, São Paulo, Brazil) at 28 °C and 120 rpm for 120 h. After incubation, the CEE was filtered to remove the biomass and centrifuged to obtain the enzymatic supernatant (CEE), which was used for further characterization.
2.3. Characterization of the CEE
2.3.1. Chemical Composition of the CEE
The centesimal composition of the CEE—including protein, lipid, ash, and carbohydrate content—was determined according to the methods established by the Association of Official Analytical Chemists (AOAC). Total nitrogen was quantified using the Micro-Kjeldahl method 960.52 [21], applying a nitrogen-to-protein conversion factor of 4.38. Lipid content was determined by method 945.16 [22]; ash content by method 942.05 [23]; and moisture content by method 925.10 [21]. Carbohydrate content was estimated by difference, subtracting the sum of the measured components from 100%.
2.3.2. Toxicity of the CEE
The toxicity of the CEE was assessed based on the protocol described by Bellatto and Braguini [24] and Salama et al. [25], with slight modifications. Ten previously hatched Artemia salina nauplii were transferred to test tubes containing 5 mL of CEE diluted in 3% (w/v) saline solution. CEE was tested at 1%, 2%, 3%, and 4% (v/v) concentrations. The positive control consisted of nauplii in 5 mL of 3% (w/v) saline solution, while the negative control included nauplii in 5 mL of potassium dichromate solution (1 mg·mL−1) diluted in saline. After 24 h of incubation, the number of surviving nauplii was counted in all experimental and control groups. The mortality rate was calculated using Equation (1).
where Test represents the number of surviving nauplii in the CEE tubes, and Control represents the number of surviving nauplii in the positive control.
2.3.3. Antioxidant Activity, Total Phenolic Compounds (TPC), and Total Flavonoid Content (TFC)
The antioxidant activity of the CEE, as well as its total phenolic content (TPC) and total flavonoid content (TFC), were assessed using the free radical scavenging methods DPPH (2,2-diphenyl-1-picrylhydrazyl), ABTS (2,2-azinobis (3-ethylbenzothiazoline-6-sulfonic acid)), and the ferric reducing antioxidant power (FRAP) assay.
For the DPPH assay, 50 μL of extract and 1.95 mL of DPPH solution were combined in test tubes, vortexed, and incubated in the dark for 30 min. Absorbance was measured at 517 nm using a UV-VIS spectrophotometer (Q898DPT, Quimis, São Paulo, Brazil) [26].
In the ABTS assay, 3 mL of ABTS solution was mixed with 30 μL of CEE, vortexed, and incubated in the dark for 2 h. Absorbance was measured at 734 nm [27].
For the FRAP assay, 100 μL of extract and 3.4 mL of FRAP reagent were mixed and incubated in a water bath at 37 °C for 30 min. Absorbance was recorded at 593 nm [28]. Results for DPPH, ABTS, and FRAP assays were expressed in µmol Trolox equivalents (TE) per gram of dry extract (gDE).
TPC was determined using a modified Folin–Ciocalteu method [29]. Briefly, 20 μL of extract was mixed with 1.68 mL of distilled water and 100 μL of Folin–Ciocalteu reagent. After 3 min, 200 μL of 20% (w/v) sodium carbonate was added. The mixture was vortexed and kept in the dark for 60 min, after which absorbance was read at 760 nm. Results were expressed as mg gallic acid equivalents (GAE) per gram of dry extract (gDE).
TFC was determined following the method described by Arriola et al. [30]. A 1 mL aliquot of CEE was mixed with 0.3 mL of 5% (w/v) sodium nitrite and 0.3 mL of 10% (w/v) aluminum chloride. After 6 min of incubation in the dark, 2 mL of 1 M NaOH was added, vortexed, and absorbance measured at 425 nm. Results were expressed as mg catechin equivalents (CE) per gram of dry extract (gDE).
2.3.4. Antibacterial Activity
The antibacterial activity of the CEE was evaluated using the well diffusion method against Staphylococcus aureus and Escherichia coli, according to protocols established by the Clinical and Laboratory Standards Institute [31]. Bacterial cultures were incubated overnight on brain heart infusion agar (BHI; Kasvi, Pinhais, Paraná, Brazil) at 35 °C for 24 h. Suspensions were prepared in 0.85% (w/v) saline and adjusted to a turbidity equivalent to 0.5 McFarland standard (~10⁸ CFU·mL−1). The pour plate technique was used to inoculate the bacteria into the agar, and 5 mm wells were made. Then, 20 μL of CEE and chloramphenicol (3%, w/v; positive control) were added to the wells. Plates were incubated at 35 °C for 24 h. Inhibition zones were measured as the diameter of the clear zone minus the diameter of the well.
2.4. Downstream Processing (Purification)
Purification was carried out by membrane separation using ultrafiltration (UF) units (cut-off, 10 kDa and 100 kDa, Vivaspin 6, GE®, Buckinghamshire, UK). A 5 mL aliquot of the CEE was added to a 100 kDa UF membrane and centrifuged at 4000 rpm for 15 min, with brief pauses every 5 min to allow sample cooling. The permeate collected from the 100 kDa UF membrane was subsequently transferred to a 10 kDa UF membrane and centrifuged under the same conditions. The retentate—partially purified enzyme (PE)—retained on the 10 kDa membrane was collected and used for the characterization. Throughout the purification process, the temperature was maintained between 4 °C and 10 °C.
2.5. Evaluation and Characterization of the Enzyme Present in the CEE
Enzymatic activity was evaluated under various conditions, including pH, temperature, presence of metal ions, and thermal stability. The CEE was analyzed in its centrifuged form, while the PE underwent further characterization to determine optimal enzymatic conditions, starch hydrolysis efficiency, lyophilization stability, and molecular weight via SDS-PAGE.
2.5.1. Enzymatic Activity
α-Amylase activity was determined following the method proposed by Fuwa [32], with modifications by Paludo et al. [18]. An aliquot of 200 µL of the enzyme (CEE or PE), diluted 1:20 in 0.1 M acetate (NaOAc, ≥99% w/w, Dinâmica Química Contemporânea, Diadema, SP, Brazil) buffer, was mixed with 200 µL of a 1% (w/v) starch ((C6H10O5)n PA; Neon Reagentes Analíticos, Suzano, SP, Brazil) solution prepared in the same buffer (pH 6.0). The mixture was incubated in a water bath at 50 ± 2 °C for 15 min. The reaction was stopped by adding 400 μL of 2 M acetic acid (AcOH, 99.8% w/w, Sigma-Aldrich, St. Louis, MO, USA), 20 mL of distilled water, and 400 μL of iodine/iodide solution [0.2% (w/v) iodine (I PA-ACS, 99.8% w/w, Êxodo Científica, Hortolândia, SP, Brazil), 2% (w/v) potassium iodide (KI P.A. ≥99% w/w, Synth, Diadema, SP, Brasil), and distilled water in a 1:1:3 ratio]. Absorbance was measured at 700 nm. Enzyme activity was expressed in U·mL−1, where one unit (U) corresponds to the amount of enzyme that hydrolyzes 0.1 mg of starch per mL per minute under the assay conditions.
2.5.2. Effect of Temperature, pH, and Metal Ions on Enzymatic Activity
The effects of temperature, pH, and metal ions on the enzymatic activity of CEE and PE were assessed individually, following the methodologies proposed by Paludo et al. [18] and Frantz et al. [15].
The temperature effect was evaluated at 20, 30, 40, 50, 60, 70, and 80 °C. The pH effect was verified at 4.0, 4.5, 5.0, 5.5, 6.0 (0.1 M acetate buffer), 6.5, 7.0, 7.5, 8.0, and 8.5 [0.1 M phosphate buffer (KH₂PO₄, ≥99% w/w, Dinâmica Química Contemporânea, Diadema, SP, Brazil)]. The effect of metal ions was evaluated during the enzymatic reaction in the presence of MnSO₄·H₂O (≥99% w/w, Neon Reagentes Analíticos, Suzano, SP, Brazil), MgSO₄ (≥99% w/w, Dinâmica Química Contemporânea, Diadema, SP, Brazil), CaCl₂·2H₂O (≥99% w/w, Synth, Diadema, SP, Brazil), and FeSO₄·7H₂O (≥98% w/w, Êxodo Científica, Hortolândia, SP, Brazil) at 1.0, 2.5, and 5.0 mM, in 0.1 M acetate buffer (pH 6.0). The activity was quantified as described in Section 2.5.1.
2.5.3. Thermal Stability of the Enzyme
The thermal stability of CEE and PE was evaluated at 40, 50, and 60 °C in a water bath over 3 h. Aliquots were collected every 10 min during the first hour, and subsequently at 2 and 3 h. Enzyme activity was measured as previously described (Section 2.5.1). An additional test was performed using acetate buffer (0.1 M) supplemented with 2.5 mM calcium to assess the stabilizing effect of calcium ions.
2.5.4. Assessment of Starch Degradation and Glucose Release
To evaluate hydrolytic activity, 100 μL of CEE or PE (with an enzyme activity of approximately 140 U·mL−1) was added to 1.9 mL of a 3% (w/v) starch solution and incubated at 50 °C for 180 min. Samples were withdrawn every 20 min, cooled in an ice bath, and analyzed for starch and glucose content. Starch concentration was determined using the iodine/iodide method [18,32], and glucose (C₆H₁₂O₆, ≥99% w/w; Synth, Diadema, SP, Brazil) content was measured using the glucose oxidase–peroxidase (GOD/POD) method [33,34].
2.5.5. Evaluation of Enzymatic Activity After Lyophilization
Both CEE and PE were lyophilized using a benchtop freeze-dryer (Liobras, Liotop L101, São Carlos, Brazil) at −45 ± 2 °C under 1 Pa pressure for 16 h, using a vacuum pump (D.V.P., RC. 8D, Italy; nominal flow rate of 10.2 m3·h−1). Enzymatic activity was assessed after lyophilization as described in Section 2.5.1.
2.6. Storage Stability of the CEE
The storage stability of the CEE was monitored by measuring its enzymatic activity (as described in Section 2.5.1) after storage at 0 °C (freezing), 4 °C (refrigeration), and 25 °C (room temperature) for a period of 721 days.
2.7. Determination of Enzyme Molecular Weight of PE by SDS-PAGE
The molecular weight of α-amylase was determined by sodium dodecyl sulfate-polyacrylamide gel electrophoresis (SDS-PAGE) according to Laemmli [35], with protocols adapted from Spier et al. [36]. This analysis was performed only for the PE, as the components in the CEE interfered with electrophoretic resolution. All reagents used for the SDS-PAGE analysis were purchased from Sigma-Aldrich® (St. Louis, MO, USA).
2.8. Statistical Analysis
All experiments were conducted in triplicate. Data were analyzed using Statistica® 7.0 software (StatSoft®, Tulsa, OK, USA). Comparisons among means were performed using Tukey’s test at a 95% confidence level (p < 0.05).
3. Results and Discussion
3.1. Proximate Composition of CEE
The CEE was characterized in terms of its proximate composition to provide a comprehensive understanding of its physicochemical properties and to assess its feasibility for potential applications, including suitability for human consumption. As expected for an aqueous extract, the CEE exhibited a high moisture content (97.01 ± 0.015%) and relatively low levels of ash (0.14 ± 0.02%), lipids (0.08 ± 0.01%), proteins (1.13 ± 0.13%), and carbohydrates (1.64 ± 0.15%) on a wet basis. Despite being derived from a liquid matrix, the nutritional composition is notable when considering the dry fraction, with protein and carbohydrate contents reaching approximately 38% and 55%, respectively.
Stilinović et al. [37] reported protein and carbohydrate contents of 23.07% and 40.42%, respectively, in lyophilized C. comatus. Compared to their findings, the CEE in the present study exhibited higher values on a dry basis.
The protein content found in the CEE can be attributed to the presence of α-amylase, as confirmed by enzymatic activity assays and SDS-PAGE analysis, as well as to residual biomass from C. comatus and proteins derived from the substrate (LGF). Similarly, the carbohydrate content likely originates from both fungal biomass and residual starch in the LGF. While the low solid content of CEE may limit direct nutritional applications, it represents an advantage in bioprocesses where a diluted medium facilitates enzyme activity and diffusion.
3.2. Toxicity Test
The acute toxicity assay with A. salina enables the determination of the median lethal dose (LD₅₀), defined as the concentration required to cause 50% mortality in the test population [38]. Figure 2 presents the results of the toxicity assay using A. salina. According to the World Health Organization (WHO), substances with an LD₅₀ below 1000 µg·mL−1 are considered toxic, while those with an LD₅₀ between 100 and 500 µg·mL−1 are classified as mildly toxic. Extracts with an LD₅₀ above 1000 µg·mL−1 are considered non-toxic [24,38]. In the present study, concentrations above 1000 µg·mL−1 of the CEE were tested, and no LD₅₀ was reached, as shown in Figure 2. Therefore, the CEE was not considered toxic at any of the concentrations evaluated.
Figure 2.
Percentage of Artemia salina nauplii mortality in saline solution at various concentrations of CEE after 24 h incubation at 26 °C.
The positive control (seawater) exhibited a 10% mortality rate under the tested conditions (26 ± 2 °C for 24 h), whereas the negative control, potassium dichromate (K₂Cr₂O₇) at 1000 µg·mL−1, resulted in 100% mortality under the same conditions.
As illustrated in Figure 2, a CEE concentration of 5380 µg·mL−1 caused approximately 37% mortality of the nauplii. Mortality rates of 25%, 27%, and 29% were observed for concentrations of 1345 µg·mL−1, 2690 µg·mL−1, and 4035 µg·mL−1, respectively.
The mortality rates observed in this study were lower than those reported by Vega-Villasante et al. [39] for the macromycete Psilocybe cubensis, which showed 40% mortality at aqueous extract concentrations between 10 and 50 µg·mL−1. At higher concentrations, mortality increased to 55%, with an LD₅₀ of 135 µg·mL−1.
In comparison, the edible mushroom Tylopilus violatinctus exhibited an LD₅₀ of 51 µg·mL−1, Hygrophorus russula had an LD₅₀ of 81 µg·mL−1, and Cantharellus cibarius showed an LD₅₀ of 105 µg·mL−1 [40]. These findings underscore the low toxicity of C. comatus in comparison with other edible mushroom species. Ruiz-González et al. [40] also evaluated Hygrophoropsis aurantiaca and Macrolepiota mastoidea, which exhibited no detectable toxicity under the applied methodological parameters.
Nieto et al. [41] assessed Pleurotus pulmonarius and Pleurotus ostreatus, and, consistent with the results of the present study, both strains demonstrated no toxicity, with LD₅₀ values exceeding 1000 µg·mL−1. Similarly, Dharmasena et al. [42] observed very low toxicity for Pleurotus djamor, which was further reduced—by more than 150-fold—when the extract was cooked before testing.
These findings suggest that the bioactive metabolites present in the C. comatus extract are found in low concentrations under the tested conditions, contributing to its low toxicity. Consequently, the CEE may be considered safe for potential application in food products.
3.3. Antioxidant Tests, TPC, and TFC
The antioxidant potential of the CEE produced by C. comatus in submerged culture was evaluated using multiple in vitro methods. These results reflect the intrinsic antioxidant properties of the extract, which was obtained without any chemical enhancement, processing, or concentration of secondary metabolites. Notably, the extract was produced under the same conditions optimized for amylase synthesis, indicating that antioxidant compounds were co-synthesized during enzyme production.
Three complementary analytical methods were employed to comprehensively assess the antioxidant capacity of the CEE: DPPH, ABTS, and FRAP. These assays are widely adopted for evaluating antioxidant activity in food and biological extracts due to their simplicity, reproducibility, sensitivity, and relevance to different radical scavenging and redox mechanisms [43]. In addition, the concentrations of TPC and TFC were determined, as these groups are key contributors to antioxidant activity. The results obtained for the CEE are summarized in Table 1.
Table 1.
TPC, TFC, and antioxidant activity of the CEE of C. comatus as measured by DPPH, ABTS, and FRAP assays.
The DPPH antioxidant activity of the CEE was 213.34 µmol TE·gDE−1, a higher value than those reported by Bach et al. [44], who evaluated five edible mushrooms and found activity ranging from 13.12 µmol TE·gDE−1 for Flammulina velutipes to 50.64 µmol TE·gDE−1 for Agaricus brasiliensis. In contrast, the ABTS activity of the CEE (11.28 µmol TE·gDE−1) was lower than that observed by Bach et al. [44] for Lentinula edodes and A. brasiliensis, which showed values of 34.57 and 128.60 µmol TE·gDE−1, respectively.
Water-based extracts typically exhibit higher DPPH radical scavenging activity than those obtained using methanol, emphasizing the importance of polar compounds in antioxidant efficacy [45,46]. For instance, Zengin et al. [47] reported that Trametes gibbose and Trametes hirsute extracted with water showed DPPH activities of 5.86 and 6.06 µmol TE·gDE−1, respectively. In comparison, the methanol extracts of the same strains presented lower values of 4.09 and 3.09 µmol TE·gDE−1. For ABTS, antioxidant activities were 8.45 and 14.15 µmol TE·gDE−1 in water, and 8.35 and 9.68 µmol TE·gDE−1 in methanol, respectively—values comparable to those obtained in the present study.
Using the FRAP method based on reducing Fe3⁺ to Fe2⁺ ions, the CEE exhibited a relatively low value of 0.33 µmol TE·gDE−1. By comparison, Zengin et al. [47] reported FRAP activity of 3.57 and 8.96 µmol TE·gDE−1 in water and 5.50 and 6.05 µmol TE·gDE−1 in methanol for T. gibbosa and T. hirsuta, respectively.
Variations in antioxidant activity across studies tend to be attributed to several factors, including fungal species, extraction method, solvent polarity, and the fungal part used (e.g., fruiting body, mycelium, or culture filtrate) [46,48].
It is important to note that the different assays applied herein operate through distinct mechanisms: DPPH and ABTS are based on free radical scavenging. At the same time, FRAP assesses the electron-donating capacity via iron ion reduction. These mechanistic differences may account for the observed variation in antioxidant values among methods.
The TPC in the CEE was 8.01 mg GAE·gDE−1, which is similar to values reported by Silva [49] for methanol extracts of edible macromycetes. For example, Pleurotus eryngii exhibited 9.19 mg GAE·gDE−1, Cantharellus cibarius had 2.58 mg GAE·gDE−1, and Pleurotus ostreatus yielded around 4 mg GAE·gDE−1. In contrast, Reis et al. [50] reported 12.54 mg GAE·gDE−1 for P. ostreatus, and Orhan and Ustun [51] found 31.48 mg GAE·gDE−1 for C. cibarius, both using ethanol as the solvent. Fonseca [52] also observed a wide range of TPC values in P. ostreatus (25–56 mg GAE·gDE−1), depending on the culture medium. Strain-specific differences were also noted: Panus lecomtei and Fistulina hepatica reached 52 and 25 mg GAE·gDE−1, respectively, even when cultivated on the same substrate.
Martínez-Escobedo et al. [53] evaluated four macromycete strains and reported low TPC values for Lycoperdon perlatum (6.05 mg GAE·gDE−1) and Astraeus hygrometricus (1.54 mg GAE·gDE−1), while Laccaria laccata (8.75 mg GAE·gDE−1) and Amanita rubescens (20.93 mg GAE·gDE−1) exhibited higher values.
The TFC of the CEE was considerably higher (285.39 ± 3.53 mg CE·gDE−1) than those reported by Boonthatui et al. [54], who investigated Schizophyllum commune at different stages of maturation and observed values ranging from 0.422 to 0.910 mg CE·gDE−1. Such differences may result from oxidative stress, which stimulates the biosynthesis of defense-related secondary metabolites [54]. A similar mechanism may explain the high flavonoid content observed in the current study.
Antioxidant compounds in the CEE are noteworthy because they are synthesized naturally and extracted without chemical solvents or external stimuli. Furthermore, these compounds can enhance the oxidative stability of food products when the CEE is incorporated as a functional ingredient.
3.4. Antibacterial Activity of CEE
The antibacterial activity of various mushroom species has been widely investigated. Keypour et al. [55] reported positive results using a chloroform extract of Ganoderma lucidum, while Quereshi et al. [56] observed antibacterial activity in acetone extracts of the same species. Kandasamy et al. [57] demonstrated a significant inhibitory effect of Pleurotus sajor-caju against multidrug-resistant Salmonella typhi.
Several studies have also reported the antimicrobial activity of C. comatus [58]. According to Modi et al. [59], both methanolic and aqueous extracts of C. comatus showed inhibition zones ranging from 13 to 20 mm and 14 to 21 mm, respectively, against Salmonella typhi (MTCC-733), E. coli (MTCC-425), and Bacillus cereus (MTCC-430). Kalaw and Albinto [60] observed a 14 mm inhibition zone against S. aureus using acetone and ethanol extracts. De Carvalho et al. [61] also confirmed the antibacterial activity of this macromycete against S. aureus.
Despite previous reports confirming the antimicrobial potential of C. comatus, the present study did not observe any inhibition against E. coli or S. aureus when using the CEE and the agar well diffusion method (Figure 3). This lack of activity could be attributed to the dilution of the extract or the possibility that bioactive antimicrobial compounds were not effectively synthesized or released into the CEE under the tested conditions.
Figure 3.
Antibacterial activity of the CEE against E. coli and S. aureus using the agar well diffusion method.
Several factors may explain the absence of antibacterial activity in this study. First, the concentration of antimicrobial compounds in the CEE may have been insufficient to produce detectable inhibition zones, possibly due to extract dilution or low solubility of bioactive compounds in the aqueous matrix. Moreover, the efficacy of the agar diffusion method depends on the ability of the compounds to diffuse adequately through the medium. Variables such as temperature, humidity, and pH can significantly affect diffusion rates and, thus, the extent of inhibition zones [62].
In addition, the physicochemical properties of the evaluated compounds, such as molecular weight, solubility, and diffusion coefficient, may limit their mobility within the culture medium, consequently affecting their detectability [63].
The agar diffusion method may also be less sensitive than quantitative methods such as the broth microdilution assay, particularly when assessing extracts with low concentrations of antimicrobial compounds. In such cases, weakly active compounds may go undetected [64].
Avci, Avci, and Köse [65] highlighted that the antibacterial activity of mushrooms—including Ganoderma lucidum, Lentinus edodes, and Coprinus macaceus—can vary depending on the extraction solvent. Their study found that while aqueous extracts produced little to no inhibition, extracts prepared with ethanol or chloroform achieved inhibition zones of up to 15 mm.
Therefore, the discrepancy between the findings of the current study and those reported in the literature underscores the importance of optimizing experimental parameters, including extract concentration, solvent selection, and the method used to assess antimicrobial activity. Future approaches such as extract fractionation, solvent-based extraction techniques, and identifying specific bioactive compounds may provide further insight into the antimicrobial potential of C. comatus and its therapeutic applications.
3.5. Evaluation and Characterization of the Enzyme Present in CEE and PE
3.5.1. Effect of Temperature, pH, and Metal Ions on the Enzymatic Activity of CEE
The enzymatic activity of α-amylase in the CEE was evaluated under different conditions, including temperature (Figure 4), pH (Figure 5), and the presence of metal ions (Table 2). These parameters are known to influence enzymatic performance and stability significantly.
Figure 4.
Relative enzymatic activity of CEE and PE at different temperatures (20, 30, 40, 50, 60, 70, and 80 °C). Different letters indicate statistically significant differences (p ≤ 0.05). Tukey’s test was performed separately for CEE and PE.
Figure 5.
Relative enzymatic activity of CEE and PE across different pH values. Different letters indicate statistically significant differences (p ≤ 0.05). Tukey’s test was performed separately for CEE and PE.
Table 2.
Influence of metal ions on the relative activity (%) of α-amylase from CEE and PE.
Figure 4 illustrates the effect of temperature on the enzymatic activity of both CEE and PE. The α-amylase showed maximum activity at 50 °C in both the CEE and the PE samples. Remarkably, the enzyme maintained over 40% of its activity at 40 °C and 60 °C, and about 31% at 20 °C and 30 °C. However, activity sharply declined by more than 92% at 70 °C and 80 °C, likely due to thermal denaturation [66]. Statistical analysis (Tukey’s test, p ≤ 0.05) revealed significant differences in enzymatic activity between 20 °C and 60 °C for CEE, whereas no significant differences were observed between 70 °C and 80 °C. For PE, no significant differences were found between 20 °C and 30 °C, or between 70 °C and 80 °C.
Previous studies support these findings. Frantz et al. [15] and Paludo et al. [18] also identified 50 °C as the optimal temperature for α-amylase from C. comatus. Frantz et al. [15] observed over 60% activity at 60 °C and more than 80% at 40 °C, while Paludo et al. [18] reported about 40% activity at 30, 40, and 60 °C, with a 92% reduction at 70 °C. Similar optimal temperatures have been reported for α-amylases from Rhizopus oryzae [67], Trichoderma pseudokoningii [68], and Aspergillus flavus [69]. Generally, α-amylases from macromycetes show optimal activity between 25 °C and 60 °C [70]. Enzymes active below gelatinization temperature are particularly valuable for reducing energy costs in industrial applications [71].
As shown in Figure 5, the optimal pH for CEE α-amylase activity was pH 5.5 (relative activity 116%). The enzymatic activity at pH 5.5 differs statistically from the others (p < 0.05). However, no significant difference (p > 0.05) was observed compared to pH 6.0 (relative activity 100%). The enzyme retained over 90% activity between pH 4.5 and 5.0 and 79% at pH 4.0. However, activity decreased substantially under basic conditions: pH 7.5–8.5 resulted in less than 20% relative activity. This decline is likely due to alterations in the ionization state of amino acids involved in catalysis [66].
For PE, the optimal pH was 5.00 (relative activity 116%), and the activity at this pH statistically differed from the others (p < 0.05). The enzyme retained around 100% activity at pH 5.5 and 6. However, similar to CEE, under basic conditions (pH 7.5–8.5), the activity decreased by less than 40%.
These results align with previous studies. Paludo et al. [18] and Frantz et al. [15] reported optimal pH values of 6.0 and 5.0, respectively, for C. comatus amylase. Other macromycetes, such as Hericium erinaceum [72] and Ganoderma tsugae [73], exhibited optimal pH values ranging from 4.5 to 6.5. Similar trends have been observed in Rhizomucor miehei and R. oryzae [67,74]. Most fungal amylases demonstrate higher activity within the pH range of 4.5 to 6.5.
Table 2 shows the influence of various metal ions (Ca2⁺, Mg2⁺, Mn2⁺, Fe3⁺, Cu2⁺) at 1, 2.5, and 5 mM concentrations on α-amylase activity. Calcium significantly increased enzymatic activity at all concentrations for both CEE and PE, with the highest increase (62%) observed at 2.5 mM for CEE (p < 0.05). For PE, although the activity increased, the difference was not statistically significant. This result supports the literature, classifying α-amylase as a metalloenzyme, with calcium acting as a key cofactor. Calcium ions interact with negatively charged amino acid residues, stabilizing the enzyme’s structure and improving catalytic efficiency [66]. This interaction may have been stronger in the CEE due to additional stabilizing compounds that were not present in PE.
Magnesium also positively influenced CEE activity, particularly at 1 and 5 mM. In contrast, manganese did not significantly affect enzymatic activity, findings consistent with 25–43% increases reported in previous studies [15,18,75]. For PE, the only significant enhancement was observed with 2.5 mM Mg2⁺ (6% increase), while other ions led to either minor improvements or reductions in activity.
Conversely, both copper and iron ions inhibited enzymatic activity. For CEE, copper caused a 41% reduction, and for PE, a 29% reduction. Singh et al. [76] also observed substantial inhibition of α-amylase by iron in Streptomyces sp., with losses of up to 50%. Interestingly, PE exhibited better resistance to ion-induced inhibition than CEE.
Conformational changes in α-amylase can directly impact its catalytic efficiency [77]. The enzyme’s active site is complex and sensitive to environmental factors, including the presence of specific metal ions, which may alter its tertiary structure and compromise function [78].
Understanding the optimal operating conditions for α-amylase from C. comatus is fundamental to future applications. These parameters help determine its suitability for baking, brewing, syrup production, wastewater treatment, and detergent formulation. Optimizing these factors can enhance process efficiency and reduce operational costs. The results also show that high temperatures or salt concentrations are not essential for maximizing enzyme performance. Enzymes that are more stable in the presence of metal ions are better suited to complex matrices, whereas more sensitive enzymes may be advantageous in simpler, well-defined systems.
Additionally, considering that the 120 h production time remains high by industrial standards, further investigations are essential to optimize the process, reduce the CEE production timeframe, and align it with scale-up requirements. In a previous study, Paludo et al. [79] demonstrated that significant levels of α-amylase from C. comatus were detectable after 96 h during a 240 h enzyme production period. These findings underscore the importance of continued optimization efforts and reinforce the potential of C. comatus CEE as a viable alternative for industrial α-amylase applications, paving the way for more efficient and economically competitive processes.
3.5.2. Thermal Stability of CEE and PE
CEE was incubated at 40, 50, and 60 °C for 180 min, and the thermal behavior at each temperature is shown in Figure 6a. The behavior of PE is shown in Figure 6b.
Figure 6.
Thermal stability of α-amylase at 40, 50, and 60 °C, with and without 2.5 mM calcium for (a) CEE and (b) PE.
At 40 °C, approximately 65% of the enzymatic activity was retained within the first 40 min, decreasing to 58% at 60 min, 40% at 120 min, and 38% at 180 min. At 50 °C, only 20% of the initial activity remained after 20 min, while no activity was detected at 60 °C after just 10 min.
Thermal stability assays with 2.5 mM calcium supplementation improved enzymatic activity by 30% at 40 °C and 20% at 50 °C. However, no improvement was observed at 60 °C. After 40 min of incubation, the enzyme maintained relatively stable activity at 40 and 50 °C, with or without calcium. This indicates that, although reduced, enzymatic activity can still support starch hydrolysis at these temperatures, suggesting potential application in long-duration processes.
For PE (Figure 6b), 36.54% of activity was retained after 60 min at 40 °C and remained stable for 3 h. At 50 °C, 24.35% activity was observed at 20 min, decreasing to 13.68% at 60 min and 12.71% at 180 min. At 60 °C, the enzyme lost all activity within minutes. Similar observations were reported by Kalia et al. [80] and Rodrigues et al. [81], who found enhanced stability at 40–50 °C for α-amylase from Aspergillus niger.
Although thermal stability was limited, activity was improved with 2.5 mM calcium acetate. Many studies report that calcium acts as a prosthetic group essential for enzymatic activity and structural stability [82].
At 40 °C, relative activity after 60 min increased by 11% in the presence of calcium. During the first 20 min, activity remained at 46% compared to the control. At 50 °C, the enzyme retained 47% activity with calcium in the first 20 min. At 60 °C, calcium maintained only ~3% activity at 20 min, versus complete inactivation without calcium. Similar improvements in thermal stability with 2.5 mM CaCl₂ were reported by Astolpho et al. [83] using α-amylase from Bacillus licheniformis.
3.5.3. Evaluation of Starch Hydrolysis and Reducing Sugar Release
CEE and PE were applied to a 3% (w/v) starch solution at 50 °C for 180 min, and starch and glucose concentrations were monitored over time (Figure 7). Both extracts—composed primarily of α-amylase, with a possible minor presence of glucoamylase—successfully hydrolyzed starch and released reducing sugars into the medium.
Figure 7.
Starch degradation (3% w/v) and glucose release over 180 min by CEE and PE.
For CEE, 38.65% of starch was hydrolyzed after 60 min, 64.34% after 120 min, and 96.31% after 180 min using a 40-fold diluted extract. The residual starch concentration was 1.01 g·L−1. PE showed faster kinetics, hydrolyzing 82.52% at 60 min, 96.84% at 120 min, and 99.78% at 180 min. At 120 min, only 0.79 g·L−1 of starch remained. With a 100-fold diluted PE, starch decreased from 25.18 g·L−1 to 0.06 g·L−1 over 180 min.
In concentrated form, the enzyme degraded 20 g·L−1 of starch in less than 5 min (unpublished data). Despite the relative enzymatic activity being ~13% at 120 min (at 50 °C), the CEE still achieved near-complete hydrolysis, indicating strong catalytic efficiency even with reduced stability.
CEE released 5.47, 8.13, and 10.85 g·L−1 of reducing sugars at 60, 120, and 180 min, respectively—representing a 7.77-fold increase. PE released glucose concentrations of 7.6, 11, and 14.5 g·L−1 over the same time points, corresponding to an 8-fold increase from the initial concentration of 1.79 g·L−1. Approximately 57% of the starch was converted to glucose.
These results suggest that α-amylase from C. comatus has promising industrial potential in applications requiring sugar release, such as baking, brewing, or syrup production. However, further studies using different substrates are necessary to fully understand its catalytic profile and behavior under varying conditions.
3.5.4. Enzymatic Activity After Lyophilization of CEE
As expected, the lyophilized CCE (LCEE) appeared gelatinous and exhibited substantially higher enzymatic activity—8933 U·mL−1—representing a 63-fold increase compared to the original CEE (142 U·mL−1). LCEE degraded over 20 g·L−1 of a 30 g·L−1 starch solution in less than 5 min at 50 °C, even when diluted.
Although the lyophilization process improves enzymatic concentration and activity, it is costly and, in this study, resulted in low yield (~2%), likely due to low solids in the culture medium. For slower processes (e.g., 2–3 h), using non-lyophilized CEE remains more cost-effective.
While LCEE demonstrates superior performance, CEE is a viable, low-cost alternative with notable enzymatic and antioxidant properties, suitable for baking, brewing, syrup, and detergent production applications.
In contrast, lyophilized purified enzyme (LPE) showed an 18.88-fold increase in activity compared to the original PE. However, the purification and lyophilization costs were significantly higher. In this context, the CEE demonstrates its potential as the most viable solution for reducing costs and enabling industrial applications.
3.6. Stability of CEE at Freezing, Refrigeration, and Room Temperatures
The stability of the crude enzymatic extract (CEE) was evaluated at three different storage temperatures—freezing (0 °C), refrigeration (4 °C), and room temperature (approximately 25 °C)—over a period of 368 days, with an additional assessment at day 721, focusing exclusively on temperature as a factor influencing enzymatic preservation (Figure 8). The α-amylase produced by C. comatus exhibited exceptional long-term stability, maintaining significant enzymatic activity even after more than one year of storage.
Figure 8.
Enzymatic activity of the crude enzymatic extract (CEE) over 721 days at freezing (0 °C), refrigeration (4 °C), and room temperature (±25 °C).
At refrigeration (4 °C) and freezing (0 °C) temperatures, the enzyme retained more than 60% of its original activity. In contrast, this preservation was not observed under room temperature conditions. Within just 7 days of storage at 25 °C, enzymatic activity had declined by 52%, and from day 61 to day 175, activity stabilized at approximately 15%. By day 368, the enzymatic activity had ceased entirely.
For comparison, a lipase produced by Aspergillus niger retained only 16% of its activity after 60 days and lost all activity within 150 days, even under refrigeration [84]. On the other hand, a phytase from the same fungus maintained 57.5% activity after 180 days at 4 °C without preservatives [36]. Many studies assessing enzyme stability rely on adding preservatives or immobilization techniques. However, few have evaluated the natural stability of enzymes stored without processing or additives.
This study is the first to report the long-term temperature-based storage stability of α-amylase extracted from C. comatus. The ability of the enzyme to retain more than 60% of its activity for over two years without preservatives underscores its inherent stability at low temperatures. These findings suggest that even minimal addition of stabilizing agents could further enhance the shelf-life and applicability of CEE for industrial or food-related applications.
3.7. Determination of PE Molecular Weight via SDS-PAGE
After partial purification by ultrafiltration (100 and 10 kDa membranes), SDS-PAGE analysis was performed to determine the molecular weight of the enzymes present in the PE. A distinct band was observed at approximately 67 kDa (Figure 9), consistent with the molecular size of standard albumin, confirming the presence of α-amylase.
Figure 9.
SDS-PAGE of purified α-amylase: (A) molecular marker; (B) purified enzyme. The standard proteins used were the following: Phosphorylase b (97 kDa), Albumin (66 kDa), Ovalbumin (45 kDa), Carbonic anhydrase (30 kDa), Trypsin inhibitor (20.1 kDa), and α-Lactalbumin (14.4 kDa).
A second band at approximately 35 kDa was also detected and tentatively identified as glucoamylase, which was supported by the enzymatic activity (~3.1 U·mL−1) observed in the partially purified extract.
The presence of only two visible bands on the SDS-PAGE gel demonstrates the effectiveness of the ultrafiltration process in producing a sample with satisfactory protein purity. The 67 kDa molecular weight observed for α-amylase aligns with previous findings: 68 kDa in Aspergillus oryzae [85], 71 kDa in Trichoderma reesei [80], and 54 kDa in Aspergillus flavus [69]. Rhizopus oligosporus amylase was reported at ~60 kDa by Egbune et al. [86].
These values confirm the molecular identity of α-amylase in the present study and reinforce its relevance for industrial use. Molecular weight plays a key role in enzymatic applications, influencing diffusivity, catalytic efficiency, thermal stability, and ease of recovery. Smaller enzymes tend to be more efficient in heterogeneous systems, whereas larger ones are often more stable and easier to immobilize [87]. Thus, determining molecular weight is crucial for optimizing enzyme use across different processes.
4. Conclusions
This study demonstrates that a CEE rich in α-amylase, produced by C. comatus using agro-industrial by-products, exhibits a robust biocatalytic profile with significant potential for process intensification in the food and biotechnology sectors. The extract showed optimal enzymatic activity at 50 °C and pH 5.5, while maintaining substantial stability under refrigeration and freezing conditions, retaining more than 60% of its activity after nearly two years without using preservatives. Notably, adding calcium ions further enhanced enzymatic activity and thermal stability, underscoring their essential role as cofactors. The efficient hydrolysis of a 3% starch solution, resulting in near-complete degradation within 180 min, highlights the capacity of the CEE for rapid substrate conversion in industrial processes. Although lyophilization significantly increased enzymatic activity, the associated rise in production costs suggests that the direct application of CEE may represent a more cost-effective alternative. These findings support using minimally processed enzymatic extracts to streamline downstream processing, reduce environmental impact, and provide a sustainable alternative to conventional commercial enzymes. Future studies should explore the integration of CEE and PE into process design and optimization across various industrial applications, contributing to the advancement of sustainable bioprocess engineering.
Author Contributions
Conceptualization, L.C.P. and M.R.S.; methodology, L.C.P.; formal analysis, L.C.P., E.C.M.G., and L.S.C.; data curation, L.C.P.; writing—original draft preparation, L.C.P., B.P.-S., R.M.B.R., and P.I.M.; writing—review and editing, L.C.P., B.P.-S., R.M.B.R., and P.I.M.; supervision, M.R.S.; project administration, M.R.S. All authors have read and agreed to the published version of the manuscript.
Funding
Coordenação de Aperfeiçoamento de Pessoal de Nível Superior (CAPES) (nº 88882.381649/2019-1), and Conselho Nacional de Desenvolvimento Científico e Tecnológico (CNPq) (nº 306591/2021-9).
Data Availability Statement
The data presented in this study are available on request from the corresponding author.
Acknowledgments
The authors thank the Department of Biochemistry and Molecular Biology of the Federal University of Paraná (UFPR) for their support and technical assistance during this project. This work was supported by the Coordination for the Improvement of Higher Education Personnel (CAPES), a Brazilian government agency, and by the Graduate Program in Food Engineering (PPGEAL-UFPR).
Conflicts of Interest
The authors declare no conflicts of interest.
References
- Wang, J.; Zhang, Y.; Wang, X.; Shang, J.; Li, Y.; Zhang, H.; Lu, F.; Liu, F. Biochemical Characterization and Molecular Mechanism of Acid Denaturation of a Novel α-Amylase from Aspergillus Niger. Biochem. Eng. J. 2018, 137, 222–231. [Google Scholar] [CrossRef]
- Carvalho, F.; Fernandes, P. Enzymes in Sweeteners Production. In Green Bio-Processes: Enzymes in Industrial Food Processing; Parameswaran, B., Varjani, S., Raveendran, S., Eds.; Springer: Singapore, 2019; pp. 151–179. ISBN 978-981-13-3263-0. [Google Scholar]
- Jujjavarapu, S.E.; Dhagat, S. Evolutionary Trends in Industrial Production of α-Amylase. Recent Pat. Biotechnol. 2019, 13, 4–18. [Google Scholar] [CrossRef] [PubMed]
- Farooq, M.A.; Ali, S.; Hassan, A.; Tahir, H.M.; Mumtaz, S.; Mumtaz, S. Biosynthesis and industrial applications of α-amylase: A review. Arch. Microbiol. 2021, 203, 1281–1292. [Google Scholar] [CrossRef]
- Jaiswal, N.; Jaiswal, P. Thermostable α-Amylases and Laccases: Paving the Way for Sustainable Industrial Applications. Processes 2024, 12, 1341. [Google Scholar] [CrossRef]
- Adroit Market Research. Alpha Amylase Market By Type (Plants, Bacteria, Fungi), By Application (Fruit Ripening, Medical Diagnostics, Flour Improvers, Malt Production) and By Region (North America, Latin America, Asia Pacific, Europe, and Middle East & Africa), and COVID-19 Analysis—Global Forecast 2024 to 2030. Available online: https://www.adroitmarketresearch.com/industry-reports/alpha-amylase-market (accessed on 9 April 2025).
- Daiha, K.d.G.; Brêda, G.C.; Larentis, A.L.; Freire, D.M.G.; Almeida, R.V. Enzyme Technology in Brazil: Trade Balance and Research Community. Braz. J. Sci. Technol. 2016, 3, 17. [Google Scholar] [CrossRef]
- Stojković, D.; Reis, F.S.; Barros, L.; Glamočlija, J.; Irić, A.; van Griensven, L.J.I.D.; Soković, M.; Ferreira, I.C.F.R. Nutrients and Non-Nutrients Composition and Bioactivity of Wild and Cultivated Coprinus comatus (O.F.Müll.) Pers. Food Chem. Toxicol. 2013, 59, 289–296. [Google Scholar] [CrossRef]
- Poomsuk, N.; Dinawong, M.; Phimbupha, P.; Wisetsai, A.; Pattumma, P.; Arthan, S. α-Glucosidase and Tyrosinase Inhibitory Guided Isolation, Identification of Major Compound and in Silico Study from Edible Mushroom Coprinus comatus. Suranaree J. Sci. Technol. 2024, 31, 030217. [Google Scholar] [CrossRef]
- Tang, X.; Liu, B.; Deng, Q.; Zhang, R.; Li, X.; Xu, H. Strengthening Detoxication Impacts of Coprinus comatus on Nickel and Fluoranthene Co-Contaminated Soil by Bacterial Inoculation. J. Environ. Manag. 2018, 206, 633–641. [Google Scholar] [CrossRef] [PubMed]
- Wang, Y.; Zhang, B.; Chen, N.; Wang, C.; Feng, S.; Xu, H. Combined Bioremediation of Soil Co-Contaminated with Cadmium and Endosulfan by Pleurotus Eryngii and Coprinus comatus. J. Soils Sediments 2018, 18, 2136–2147. [Google Scholar] [CrossRef]
- Rouhana-Toubi, A.; Wasser, S.P.; Fares, F. The Shaggy Ink Cap Medicinal Mushroom, Coprinus comatus (Higher Basidiomycetes) Extract Induces Apoptosis in Ovarian Cancer Cells via Extrinsic and Intrinsic Apoptotic Pathways. Int. J. Med. Mushrooms 2015, 17, 1127–1136. [Google Scholar] [CrossRef]
- Stojkovic, D.; Smiljkovic, M.; Ciric, A.; Glamoclija, J.; Van Griensven, L.; Ferreira, I.C.F.R.; Sokovic, M. An Insight into Antidiabetic Properties of Six Medicinal and Edible Mushrooms: Inhibition of α-Amylase and α-Glucosidase Linked to Type-2 Diabetes. S. Afr. J. Bot. 2019, 120, 100–103. [Google Scholar] [CrossRef]
- Zhao, H.; Li, H.; Lai, Q.; Yang, Q.; Dong, Y.; Liu, X.; Wang, W.; Zhang, J.; Jia, L. Antioxidant and Hepatoprotective Activities of Modified Polysaccharides from Coprinus comatus in Mice with Alcohol-Induced Liver Injury. Int. J. Biol. Macromol. 2019, 127, 476–485. [Google Scholar] [CrossRef]
- Frantz, S.C.; Paludo, L.C.; Stutz, H.; Spier, M.R. Production of Amylases from Coprinus comatus under Submerged Culture Using Wheat-Milling by-Products: Optimization, Kinetic Parameters, Partial Purification and Characterization. Biocatal. Agric. Biotechnol. 2019, 17, 82–92. [Google Scholar] [CrossRef]
- USDA Grain. World Markets and Trade; United States Department of Agriculture Foreign Agricultural Service: Washington, DC, USA, 2021; pp. 1–11.
- Coêlho, J.D. Trigo: Produção e Mercados. In Caderno Setorial ETENE; Banco do Nordeste do Brasil: Fortaleza, Brazil, 2021; pp. 1–14. [Google Scholar]
- Paludo, L.C.; Frantz, S.C.; Ançay, R.; Stutz, H.; Dantas, T.L.P.; Spier, M.R. Optimization, Kinetic and Bioprocess Parameters of Amylases Production from Coprinus comatus under Submerged Culture Using Starch-Based Simple Medium: Partial Enzyme Characterization. Biocatal. Agric. Biotechnol. 2018, 16, 529–537. [Google Scholar] [CrossRef]
- Bhatia, K.; Mal, G.; Bhar, R.; Jyoti; Attri, C.; Seth, A. Purification and Characterization of Thermostable Superoxide Dismutase from Anoxybacillus Gonensis KA 55 MTCC 12684. Int. J. Biol. Macromol. 2018, 117, 1133–1139. [Google Scholar] [CrossRef] [PubMed]
- Kilikian, B.V.; Pessoa Júnior, A. Purificação de Produtos Biotecnológicos: Operações e Processos Com Aplicação Industrial, 2nd ed.; Blucher: São Paulo, Brazil, 2020. [Google Scholar]
- AOAC. Official Methods of Analysis of AOAC International, 16th ed.; 4 rev.; AOAC International: Arlington, VA, USA, 1998; ISBN 0935584544. [Google Scholar]
- AOAC. Official Methods of Analysis of AOAC International, 17th ed.; AOAC International: Gaithersburg, MD, USA, 2000. [Google Scholar]
- AOAC. Official Methods of Analysis of AOAC International, 15th ed.; AOAC International: Arlington, VA, USA, 1990. [Google Scholar]
- Bellatto, G.A.; Braguini, W.L. Assessment of the Use of Cooked Araucaria Angustifolia Seed Coats Extract as Food for Brine Shrimp. J. Environ. Sci. Health Part B 2020, 55, 813–819. [Google Scholar] [CrossRef]
- Salama, A.; Chavez, M.; Hinestrosa, A. Fito y bioanálisis de algunas plantas utilizadas en la medicina popular con posible actividad farmacológica. Ver. Col. Cien. Quim. Farm. 1996, 25, 44–51. [Google Scholar]
- Brand-Williams, W.; Cuvelier, M.E.; Berset, C. Use of a Free Radical Method to Evaluate Antioxidant Activity. LWT-Food Sci. Technol. 1995, 28, 25–30. [Google Scholar] [CrossRef]
- Re, R.; Pellegrini, N.; Proteggente, A.; Pannala, A.; Yang, M.; Rice-Evans, C. Antioxidant Activity Applying an Improved ABTS Radical Cation Decolorization Assay. Free Radic. Biol. Med. 1999, 26, 1231–1237. [Google Scholar] [CrossRef]
- Benzie, I.F.F.; Strain, J.J. The Ferric Reducing Ability of Plasma (FRAP) as a Measure of “Antioxidant Power”: The FRAP Assay. Anal. Biochem. 1996, 239, 70–76. [Google Scholar] [CrossRef]
- Singleton, V.L.; Rossi, J.A. Colorimetry of Total Phenolics with Phosphomolybdic-Phosphotungstic Acid Reagents. Am. J. Enol. Vitic. 1965, 16, 144–158. [Google Scholar] [CrossRef]
- Arriola, N.A.; dos Santos, G.D.; Prudêncio, E.S.; Vitali, L.; Petrus, J.C.C.; Castanho Amboni, R.D.M. Potential of Nanofiltration for the Concentration of Bioactive Compounds from Watermelon Juice. Int. J. Food Sci. Technol. 2014, 49, 2052–2060. [Google Scholar] [CrossRef]
- CLSI—Clinical and Laboratory Standards Institute. Performance Standards for Antimicrobial Disk Susceptibility Tests, 8th ed.; Clinical and Laboratory Standards Institute: Wayne, MI, USA, 2003. [Google Scholar]
- Fuwa, H. A New Method for Microdetermination of Amylase Activity by the Use of Amylose as the Substrate. J. Biochem. 1954, 41, 583–603. [Google Scholar] [CrossRef]
- Ramesh, V.; Ramachandra Murty, V. Sequential Statistical Optimization of Media Components for the Production of Glucoamylase by Thermophilic Fungus Humicola Grisea MTCC 352. Enzyme Res. 2014, 2014, 317940. [Google Scholar] [CrossRef]
- Nguyen, Q.D.; Rezessy-Szabó, J.M.; Claeyssens, M.; Stals, I.; Hoschke, Á. Purification and Characterisation of Amylolytic Enzymes from Thermophilic Fungus Thermomyces Lanuginosus Strain ATCC 34626. Enzyme Microb. Technol. 2002, 31, 345–352. [Google Scholar] [CrossRef]
- Laemmli, U.K. Cleavage of Structural Proteins during the Assembly of the Head of Bacteriophage T4. Nature 1970, 227, 680–685. [Google Scholar] [CrossRef] [PubMed]
- Spier, M.R.; Fendrich, R.C.; Almeida, P.C.; Noseda, M.; Greiner, R.; Konietzny, U.; Woiciechowski, A.L.; Soccol, V.T.; Soccol, C.R. Phytase Produced on Citric Byproducts: Purification and Characterization. World J. Microbiol. Biotechnol. 2011, 27, 267–274. [Google Scholar] [CrossRef]
- Stilinović, N.; Čapo, I.; Vukmirović, S.; Rašković, A.; Tomas, A.; Popović, M.; Sabo, A. Chemical Composition, Nutritional Profile and in Vivo Antioxidant Properties of the Cultivated Mushroom Coprinus comatus: Comprimus Comatus Properties. R. Soc. Open Sci. 2020, 7, 200900. [Google Scholar] [CrossRef]
- Meyer, B.N.; Ferrigni, N.R.; Putnam, J.E.; Jacobsen, L.B.; Nichols, D.E.; McLaughlin, J.L. Brine Shrimp: A Convenient General Bioassay for Active Plant Constituents. Planta Med. 1982, 45, 31–34. [Google Scholar] [CrossRef]
- Vega-Villasante, F.; Ruiz-González, L.E.; Guerrero-Galván, S.R.; Guzmán-Dávalos, L. Evaluación de La Toxicidad de Psilocybe Cubensis (Agaricales, Basidiomycota) Sobre Artemia Franciscana (Crustacea, Anostraca). Rev. Iberoam. Micol. 2013, 30, 54–56. [Google Scholar] [CrossRef]
- Ruiz-González, L.E.; Vázquez-Zea, J.A.; Vega-Villasante, F.; Guzmán-Dávalos, L.; Guerrero-Galván, S.R. Evaluación Del Efecto Tóxico de Hongos Basidiomycota En La Eclosión de Quistes de Artemia Franciscana. Rev. Iberoam. Micol. 2017, 34, 220–224. [Google Scholar] [CrossRef] [PubMed]
- Nieto, I.J.R.; Salama, A.M.; Cataño, J.E.P.; Chegwin, C.A. Determinación de La Toxicidad de Pleurotus Ostreatus, Pleurotus Pulmonarius y Paxillus Involutus Sobre Artemia Salina. Rev. Iberoam. Micol. 2008, 25, 186–187. [Google Scholar] [CrossRef]
- Dharmasena, W.G.B.P.; Silva, A.B.G.; Udugama, S.S.T.T.A.; Wijeyaratne, S.C.; Munasinghe, D.H.H. Domestication Potential, Acute Toxicity, and Nutritional Properties of a White Strain of Pleurotus djamor Rumph. Ex Fr. (Agaricales, Basidiomycota) from Sri Lanka. Curr. Res. Environ. Appl. Mycol. 2024, 14, 301–332. [Google Scholar] [CrossRef]
- Oliveira, V.B.; Zuchetto, M.; Oliveira, C.F.; Paula, C.S.; Duarte, A.F.S.; Miguel, M.D.; Miguel, O.G. Efeito de Diferentes Técnicas Extrativas No Rendimento, Atividade Antioxidante, Doseamentos Totais e No Perfil Por Clae-Dad de Dicksonia Sellowiana (Presl.). Hook, Dicksoniaceae. Rev. Bras. Plantas Med. 2016, 18, 230–239. [Google Scholar] [CrossRef]
- Bach, F.; Zielinski, A.A.F.; Helm, C.V.; Maciel, G.M.; Pedro, A.C.; Stafussa, A.P.; Ávila, S.; Haminiuk, C.W.I. Bio Compounds of Edible Mushrooms: In Vitro Antioxidant and Antimicrobial Activities. LWT 2019, 107, 214–220. [Google Scholar] [CrossRef]
- Nguyen, T.K.; Lee, M.W.; Yoon, K.N.; Kim, H.Y.; Jin, G.-H.; Choi, J.-H.; Im, K.H.; Lee, T.S. In Vitro Antioxidant, Anti-Diabetic, Anti-Cholinesterase, Tyrosinase and Nitric Oxide Inhibitory Potential of Fruiting Bodies of Coprinellus Micaceus. J. Mushroom 2014, 12, 330–340. [Google Scholar] [CrossRef]
- Tešanović, K.; Pejin, B.; Šibul, F.; Matavulj, M.; Rašeta, M.; Janjušević, L.; Karaman, M. A Comparative Overview of Antioxidative Properties and Phenolic Profiles of Different Fungal Origins: Fruiting Bodies and Submerged Cultures of Coprinus comatus and Coprinellus Truncorum. J. Food Sci. Technol. 2017, 54, 430–438. [Google Scholar] [CrossRef]
- Zengin, G.; Karanfil, A.; Uren, M.C.; Kocak, M.S.; Sarikurkcu, C.; Gungor, H.; Nancy Picot, C.M.; Mahomoodally, M.F. Phenolic Content, Antioxidant and Enzyme Inhibitory Capacity of Two: Trametes Species. RSC Adv. 2016, 6, 73351–73357. [Google Scholar] [CrossRef]
- Elhassaneen, Y.E.A.; Saad, H.H.; Mehram, E.B. Effect of solvents with different polarity on the extraction of bioactive compounds from reishi mushroom (Ganoderma lucidum) and their antioxidant and free radicals scavenging activities: Application in buffalo meatballs. Egypt. J. Chem. 2025, 68, 113–128. [Google Scholar] [CrossRef]
- Silva, N.G. Estudo Da Capacidade Antioxidante de Cogumelos Comestíveis. Master’s Thesis, Universidade de Coimbra, Coimbra, Portugal, 2015. [Google Scholar]
- Reis, F.S.; Martins, A.; Barros, L.; Ferreira, I.C.F.R. Antioxidant Properties and Phenolic Profile of the Most Widely Appreciated Cultivated Mushrooms: A Comparative Study between in Vivo and in Vitro Samples. Food Chem. Toxicol. 2012, 50, 1201–1207. [Google Scholar] [CrossRef]
- Orhan, I.; Üstün, O. Determination of Total Phenol Content, Antioxidant Activity and Acetylcholinesterase Inhibition in Selected Mushrooms from Turkey. J. Food Compos. Anal. 2011, 24, 386–390. [Google Scholar] [CrossRef]
- Fonseca, L.S. Fenóis Totais e Atividade Antioxidante de Cogumelos Destoxificantes e Seus Resíduos Pós-Cultivo; Trabalho de Conclusão de Curso; Universidade de Brasília: Brasília, Brazil, 2017. [Google Scholar]
- Martínez-Escobedo, N.A.; Vázquez-González, F.J.; Valero-Galván, J.; Álvarez-Parrilla, E.; Garza-Ocañas, F.; Najera-Medellin, J.A.; Quiñónez-Martínez, M. Actividad Antimicrobiana, Contenido de Compuestos Fenólicos y Capacidad Antioxidante de Cuatro Hongos Macromicetos Comestibles de Chihuahua, México. TIP Rev. Espec. Cienc. Químico-Biológicas 2021, 24, e318. [Google Scholar] [CrossRef]
- Boonthatui, Y.; Chongsuwat, R.; Kittisakulnam, S. Production of Antioxidant Bioactive Compounds during Mycelium Growth of Schizophyllum Commune on Different Cereal Media. Chiang Mai Univ. J. Nat. Sci. 2021, 20, e2021032. [Google Scholar] [CrossRef]
- Keypour, S.; Riahi, H.; Moradali, M.-F.; Rafati, H. Investigation of the Antibacterial Activity of a Chloroform Extract of Ling Zhi or Reishi Medicinal Mushroom, Ganoderma Lucidum (W. Curt.: Fr.) P. Karst. (Aphyllophoromycetideae), from Iran. Int. J. Med. Mushrooms 2008, 10, 345–349. [Google Scholar] [CrossRef]
- Quereshi, S.; Pandey, A.K.; Sandhu, S.S. Evaluation of Antibacterial Activity of Different Ganoderma Lucidum Extracts. People’s J. Sci. Res. 2010, 3, 9–13. [Google Scholar]
- Kandasamy, S.; Chinnappan, S.; Thangaswamy, S.; Balakrishnan, S.; Khalifa, A.Y.Z. Assessment of Antioxidant, Antibacterial Activities and Bioactive Compounds of the Wild Edible Mushroom Pleurotus Sajor-Caju. Int. J. Pept. Res. Ther. 2020, 26, 1575–1581. [Google Scholar] [CrossRef]
- Nowakowski, P.; Naliwajko, S.K.; Markiewicz-Żukowska, R.; Borawska, M.H.; Socha, K. The Two Faces of —Functional Properties and Potential Hazards. Phytother. Res. 2020, 34, 2932–2944. [Google Scholar] [CrossRef] [PubMed]
- Modi, H.A.; Sanjay Parihar, S.P.; Pithawala, E.A.; Jain, N.K. Preliminary Phytochemical Screening and Antibacterial Activity of Wild Edible Mushrooms Collected from Mahal Forest of Dang District, Gujarat, India. World J. Pharm. Pharm. Sci. 2014, 3, 1164–1174. [Google Scholar]
- Kalaw, S.; Albinto, R. Functional Activities of Philippine Wild Strain of Coprinus comatus (O. F. Müll.: Fr.) Pers and Pleurotus Cystidiosus, O. K. Miller Grown on Rice Straw Based Substrate Formulation. Mycosphere 2014, 5, 646–655. [Google Scholar] [CrossRef]
- de Carvalho, M.P.; Gulotta, G.; do Amaral, M.W.; Lünsdorf, H.; Sasse, F.; Abraham, W.-R. Coprinuslactone Protects the Edible Mushroom Coprinus comatus against Biofilm Infections by Blocking Both Quorum-Sensing and MurA. Environ. Microbiol. 2016, 18, 4254–4264. [Google Scholar] [CrossRef]
- Ali, F.; Silvy, T.N.; Hossain, T.J.; Uddin, M.K.; Uddin, M.S. Prevalence and Antimicrobial Resistance Phenotypes of Salmonella Species Recovered at Various Stages of Broiler Operations in Hathazari, Bangladesh. Int. J. One Health 2021, 7, 158–164. [Google Scholar] [CrossRef]
- Bonev, B.; Hooper, J.; Parisot, J. Principles of Assessing Bacterial Susceptibility to Antibiotics Using the Agar Diffusion Method. J. Antimicrob. Chemother. 2008, 61, 1295–1301. [Google Scholar] [CrossRef]
- Hossain, T.J. Methods for Screening and Evaluation of Antimicrobial Activity: A Review of Protocols, Advantages, and Limitations. Eur. J. Microbiol. Immunol. 2024, 14, 97–115. [Google Scholar] [CrossRef] [PubMed]
- Avci, E.; Alp Avci, G.; Köse, D. Determination of Antioxidant and Antimicrobial Activities of Medically Important Mushrooms Using Different Solvents and Chemical Composition via GC/MS Analyses. J. Food Nutr. Res. 2014, 2, 429. [Google Scholar] [CrossRef][Green Version]
- Tene Stephano, T.; Julie Mathilde, K.; Houketchang Serge Cyrille, N.; Boungo Gires, T.; Foffe Hermann Arantes, K.; Hilaire Macaire, W. Characterisation of Amylase Crude Extracts of Germinated Corn (Kassaï and Atp Varieties) and Sweet Potato Flours (Local and 1112 Varieties). Int. J. Adv. Res. Biol. Sci. 2018, 5, 230–240. [Google Scholar] [CrossRef]
- de Almeida, P.Z.; Pereira, M.G.; de Carvalho, C.C.; Heinen, P.R.; Ziotti, L.S.; Messias, J.M.; Jorge, J.A.; Polizeli, M.d.L.T.d.M. Bioprospection and Characterization of the Amylolytic Activity by Filamentous Fungi from Brazilian Atlantic Forest. Biota Neotrop. 2017, 17, e20170337. [Google Scholar] [CrossRef]
- Abdulaal, W.H. Purification and Characterization of α-Amylase from Trichoderma Pseudokoningii. BMC Biochem. 2018, 19, 4. [Google Scholar] [CrossRef]
- Karim, K.M.R.; Husaini, A.; Sing, N.N.; Sinang, F.M.; Roslan, H.A.; Hussain, H. Purification of an Alpha Amylase from Aspergillus Flavus NSH9 and Molecular Characterization of Its Nucleotide Gene Sequence. 3 Biotech 2018, 8, 204. [Google Scholar] [CrossRef]
- Jonathan, S.G.; Adeoyo, O.R. Evaluation of Ten Wild Nigerian Mushrooms for Amylase and Cellulase Activities. Mycobiology 2011, 39, 103–108. [Google Scholar] [CrossRef]
- Božić, N.; Lončar, N.; Slavić, M.Š.; Vujčić, Z. Raw Starch Degrading α-Amylases: An Unsolved Riddle. Amylase 2017, 1, 12–25. [Google Scholar] [CrossRef]
- Du, F.; Wang, H.X.; Ng, T.B. An Amylase from Fresh Fruiting Bodies of the Monkey Head Mushroom Hericium Erinaceum. Appl. Biochem. Microbiol. 2013, 49, 23–27. [Google Scholar] [CrossRef]
- Irshad, M. Muhammad Irshad Purification and Characterization of α-Amylase from Ganoderma Tsuage Growing in Waste Bread Medium. Afr. J. Biotechnol. 2012, 11, 3643. [Google Scholar] [CrossRef][Green Version]
- Bernardes, A.V.; Martins, E.D.S.; Da Mata, J.F.; Ferreira, O.E. Utilização de Subprodutos Agroindustriais Para Produção de α-Amilase Por Rhizomucor Miehei. Rev. Bras. Tecnol. Agroind. 2014, 8, 1439–1451. [Google Scholar] [CrossRef]
- Nwagu, T.N.; Okolo, B.N. Extracellular Amylase Production of a Thermotolerant Fusarium Sp. Isolated from Eastern Nigerian Soil. Arch. Biol. Technol. 2011, 54, 649–658. [Google Scholar] [CrossRef]
- Singh, R.; Singh, A.; Sachan, S. Enzymes Used in the Food Industry: Friends or Foes? In Enzymes in Food Biotechnology: Production, Applications, and Future Prospects; Academic Press: Cambridge, MA, USA, 2019; pp. 827–843. [Google Scholar] [CrossRef]
- Khodarahmi, R.; Yazdanparast, R. Suppression Effect of Guanidine Hydrochloride on α-Cyclodextrin-Assisted Refolding of Denatured α-Amylase. Process Biochem. 2005, 40, 2973–2979. [Google Scholar] [CrossRef]
- Wei, X.; Huang, W.; Teng, M.; Shen, H.; Feng, B.; Chen, L.; Yang, F.; Wang, L.; Yu, S. Allosteric Regulation of α-Amylase Induced by Ligands Binding. Int. J. Biol. Macromol. 2023, 243, 125131. [Google Scholar] [CrossRef]
- Paludo, L.C.; Biz, A.P.; Gonçalves, K.M.; Strobel, C.S.; Vaz, M.R.F.; Spier, M.R. Validation of Mathematical Models as a Tool for Prediction of α-Amylase Production by Coprinus comatus in a Low-Cost Culture Medium. Acta Sci.-Technol. 2023, 45, e63415. [Google Scholar] [CrossRef]
- Kalia, S.; Bhattacharya, A.; Prajapati, S.K.; Malik, A. Utilization of Starch Effluent from a Textile Industry as a Fungal Growth Supplement for Enhanced α-Amylase Production for Industrial Application. Chemosphere 2021, 279, 130554. [Google Scholar] [CrossRef]
- de Oliveira Rodrigues, P.; de Cássia Pereira, J.; dos Santos, D.Q.; Gurgel, L.V.A.; Pasquini, D.; Baffi, M.A. Synergistic Action of an Aspergillus (Hemi-)Cellulolytic Consortium on Sugarcane Bagasse Saccharification. Ind. Crops Prod. 2017, 109, 173–181. [Google Scholar] [CrossRef]
- Song, J.; Shen, X.; Liu, F.; Zhao, X.; Wang, Y.; Wang, S.; Wang, P.; Wang, J.; Su, F.; Li, S. Ca2+-Based Metal-Organic Framework as Enzyme Preparation to Promote the Catalytic Activity of Amylase. Mater. Today Chem. 2023, 30, 101522. [Google Scholar] [CrossRef]
- Astolpho, H.A.; Júnior Do Carmo, E.; Astolfi-Filho, S. Expressão e Caracterização de α-Amilase de Bacillus Licheniformis DSM13 Em Levedura Pichia Pastoris. Sci. Amazon 2017, 6, 107–118. [Google Scholar]
- Muruci, L.N.M.; Santos, R.R.S.; Viana, L.A.N.; Damaso, M.C.T.; Couri, S.; Penha, E.M. Estudo Da Estabilidade a Temperatura, PH e a Estocagem, de Lipase Produzida Por Aspergillus Niger Em Fermentação Semi-Sólida. In ENZITC—X Brazilian Seminar on Enzyme Technology; Fundação Universidade Regional de Blumenau: Blumenau, Brazil, 2012. [Google Scholar]
- Ramachandran, S.; Patel, A.K.; Madhavan Nampoothiri, K.; Chandran, S.; Szakacs, G.; Soccol, C.R.; Pandey, A. Alpha Amylase from a Fungal Culture Grown on Oil Cakes and Its Properties. Braz. Arch. Biol. Technol. 2004, 47, 309–317. [Google Scholar] [CrossRef]
- Egbune, E.O.; Avwioroko, O.J.; Anigboro, A.A.; Aganbi, E.; Amata, A.I.; Tonukari, N.J. Characterization of a Surfactant-Stable α-Amylase Produced by Solid-State Fermentation of Cassava (Manihot Esculenta Crantz) Tubers Using Rhizopus Oligosporus: Kinetics, Thermal Inactivation Thermodynamics and Potential Application in Laundry Industries. Biocatal. Agric. Biotechnol. 2022, 39, 102290. [Google Scholar] [CrossRef]
- Wu, X.; Wang, Y.; Tong, B.; Chen, X.; Chen, J. Purification and Biochemical Characterization of a Thermostable and Acid-Stable Alpha-Amylase from Bacillus Licheniformis B4-423. Int. J. Biol. Macromol. 2018, 109, 329–337. [Google Scholar] [CrossRef] [PubMed]
Disclaimer/Publisher’s Note: The statements, opinions and data contained in all publications are solely those of the individual author(s) and contributor(s) and not of MDPI and/or the editor(s). MDPI and/or the editor(s) disclaim responsibility for any injury to people or property resulting from any ideas, methods, instructions or products referred to in the content. |
© 2025 by the authors. Licensee MDPI, Basel, Switzerland. This article is an open access article distributed under the terms and conditions of the Creative Commons Attribution (CC BY) license (https://creativecommons.org/licenses/by/4.0/).